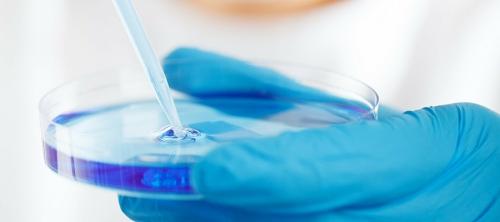
listeria monocytogenes

La Associació de Veterinaris i Higienistes de Catalunya (AVHIC) organiza una conferencia el próximo 25 de enero en la que se expondran las primeras experiencias en la aplicación del RD 1021/2022, sobre higiene alimentaria en establecimientos minoristas, y se resolveran dudas surgidas entorno a la nueva normativa.